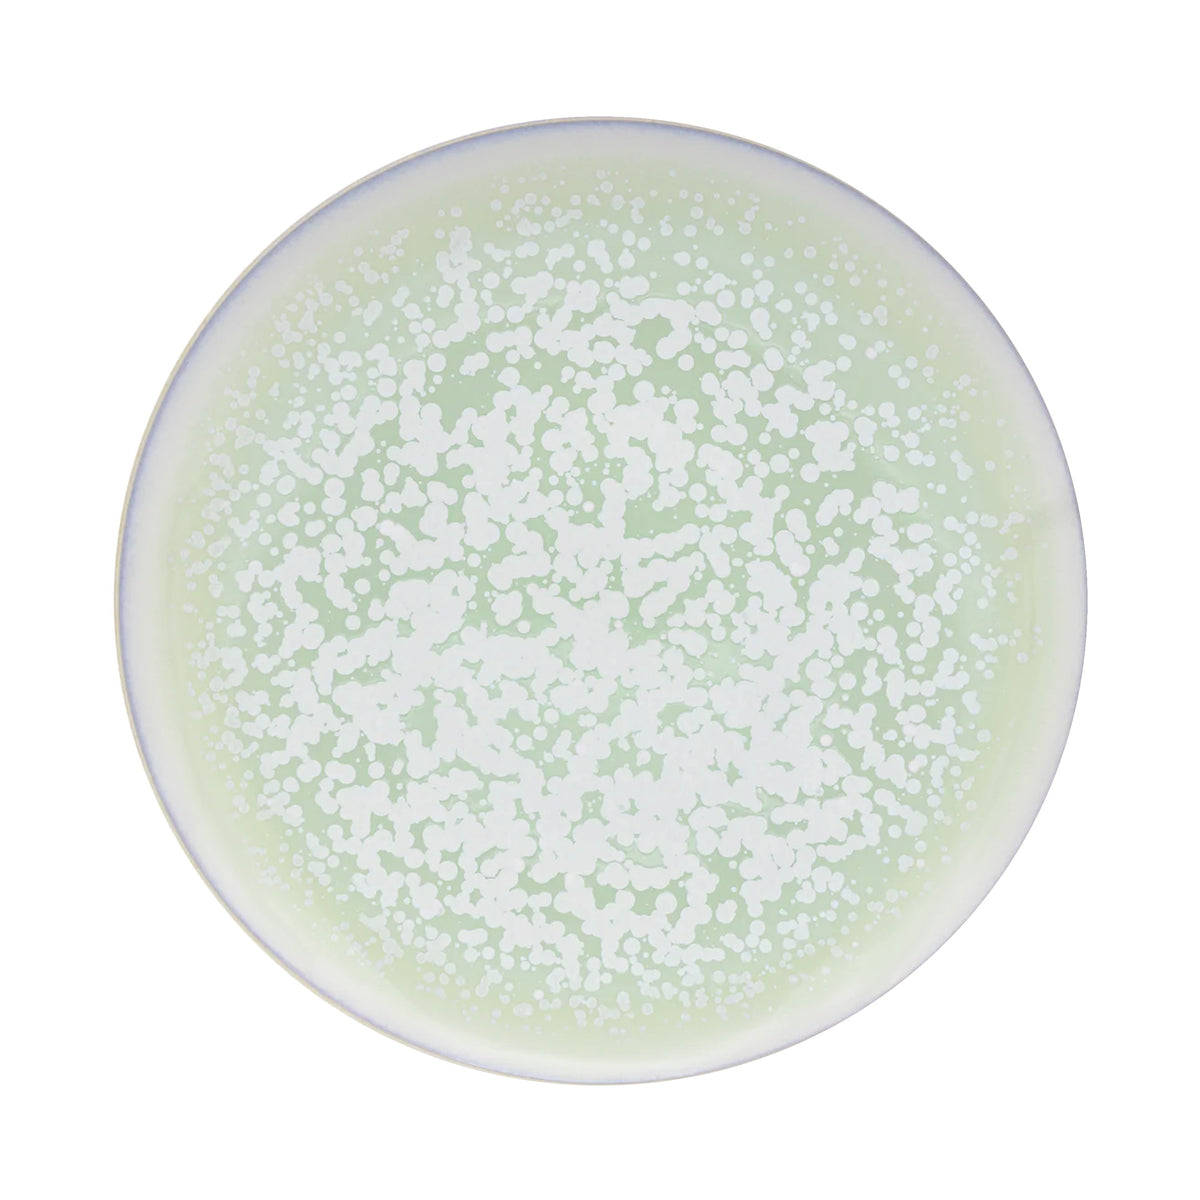
SONG Amande - Assiette 29 cm, Agora

Song
SONG Amande - Assiette de présentation, 2011

See
In stock293.00 EUR
Porcelaine de Limoges
J.L Coquet

Résultat d’un remarquable travail des émaux, la collection Song saura vous séduire par l’originalité de son décor, rendant chaque pièce unique. Subtile et minérale, cette collection est déclinée en différents coloris (Amande, Ocre,Océan, Orage, Perle et Sienne) pour vous offrir une table élégante et raffinée.
Song

See
In stock293.00 EUR
Song

See
In stock254.00 EUR
Song

See
In stock280.00 EUR
Song

See
In stock234.00 EUR
Song
See
In stock215.00 EUR
Song

See
In stock242.00 EUR
Song

See
In stock203.00 EUR
Song

See
In stock179.00 EUR
Song

See
In stock215.00 EUR
Song

See
In stock179.00 EUR
Song

See
In stock152.00 EUR
Song

See
In stock192.00 EUR
Song

See
In stock157.00 EUR
Song

See
In stock128.00 EUR
Song

See
In stock165.00 EUR
Song

See
In stock169.00 EUR
Song

See
In stock179.00 EUR
Song

See
In stock228.00 EUR
Song

See
In stock196.00 EUR
Song

See
In stock235.00 EUR
Song

See
In stock340.00 EUR
Song

See
In stock270.00 EUR